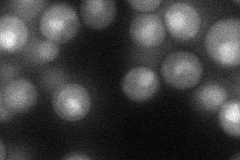
YOR068C
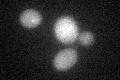
YOR068C
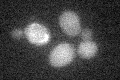
YOR068C

View description
Protein involved in vacuole morphogenesis; acts at an early step of homotypic vacuole fusion that is required for vacuole tethering
Localization:
Intensity:
Fold change:
Significance:
-
C’ GFP library in SD

below threshold15.68 -
N' NOP1pr-GFP in SD
nucleus36.7858 -
N' TEF2pr-mCherry in SD

below threshold4.3692 -
N' NATIVEpr-GFP in SD

below threshold15.1286 -
N' TEF2pr-VC and Cyto-VN in SD

#N/A0 -
C’ GFP library in SD+DTT
cytosol15.851.01No -
C’ GFP library in SD+H2O2
cytosol18.681.19No -
C’ GFP library in Starvation Media

cytosol16.531.05No -
C’ GFP library on the background of Pup2-DaMP

below threshold -
C’ GFP library on the background of CCT mutant

below threshold15.61570.995787No
